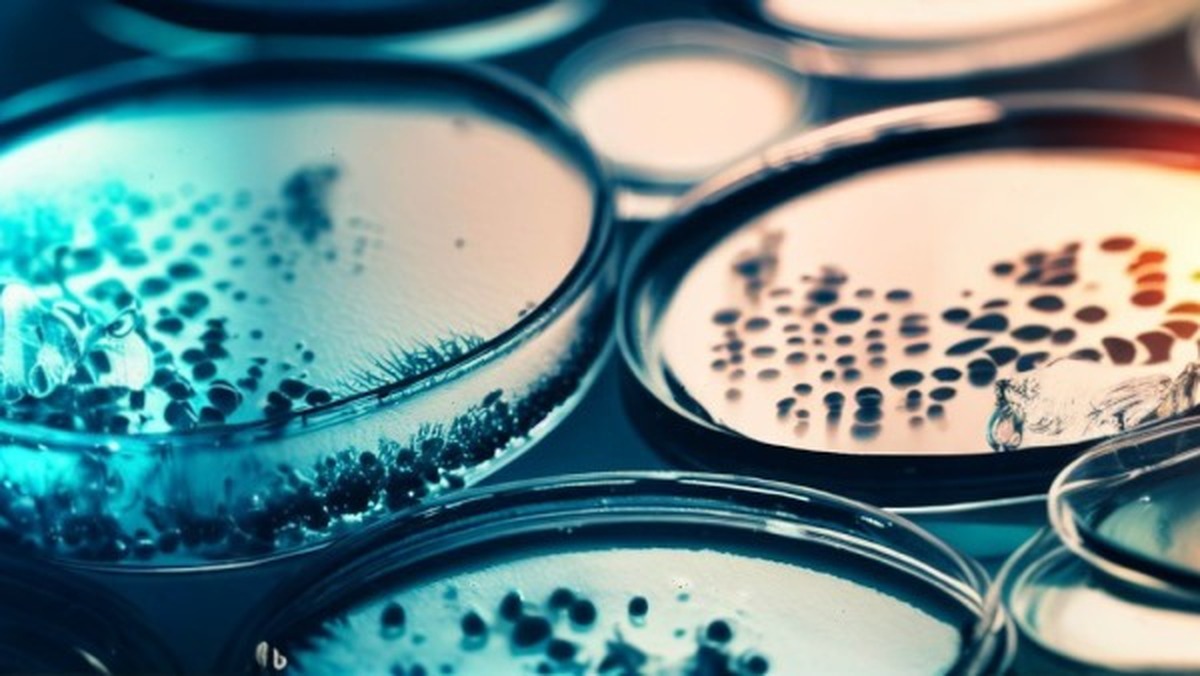
تولید ریز بافت های بالغ تر کلیوی با کشت سه بعدی

برچسب - بافت
برنا - گروه علمی و فناوری: دانشمندان با توسعه یک روش کمهزینه مبتنی بر نور موفق شدند شبکههای الیافی میکروسکوپی در مغز و سایر اندامهای بدن انسان را آشکار کنند.
کد خبر: ۲۲۹۸۶۷۱
۱۴۰۴/۱۰/۱۴
برنا - گروه علمی و فناوری: پژوهشگران کشف کردند آنزیمهایی که سلولها را به مرگ میکشانند در شرایط خاص میتوانند باعث بازسازی سریع بافت های آسیبدیده شوند.
کد خبر: ۲۲۹۵۴۴۱
۱۴۰۴/۱۰/۰۵
برنا - گروه علمی و فناوری: پژوهشگران با چاپ سهبعدی بافت های انسانی حاوی مایعات شبهخونی مدلهایی ساختند که ظاهر، حس و واکنش واقعی اعضای بدن را شبیهسازی میکنند و میتوانند ایمنی و دقت آموزش جراحان را افزایش دهند.
کد خبر: ۲۲۶۲۰۸۲
۱۴۰۴/۰۷/۰۶
برنا - گروه علمی و فناوری: یکی از شرکتهای عضو منطقه بینالمللی نوآوری ایران تاکنون بیش از یک میلیون قطعه فرآورده انسانی را تولید کرده و در خدمت درمان بیماران قرار داده است.
کد خبر: ۲۲۴۶۶۵۵
۱۴۰۴/۰۵/۲۰
فناوری که پیش از این دانش فنی آن در اختیار فقط ۹ کشور در دنیا بود.
با کمک این فناوری مرز دانشی ۲۹۵ فراورده حیاتی تولید شده که در درمان بیماریها در زمینههایی مثل ارتوپدی، جراحی قلب، سوختگی و حتی دندانپزشکی کاربرد دارند.
کد خبر: ۲۲۳۶۲۲۳
۱۴۰۴/۰۴/۱۸
اختلاف میان اداره کل راه و شهرسازی استان کرمان و شرکت گاز منطقه ۶ کشور بر سر مسیر عبور لولههای گاز در حریم لاین دوم جادههای «کرمان – راور» و «کرمان – بافت » برطرف شد.
کد خبر: ۲۲۳۲۳۰۹
۱۴۰۴/۰۴/۰۵
برنا - گروه علمی و فناوری: دانشمندان فناوری جدیدی را برای ساخت بافت های پیشرفته در زمینه پزشکی بازساختی توسعه دادهاند.
کد خبر: ۲۱۹۸۵۲۵
۱۴۰۳/۱۲/۱۹
محققان ایرانی با همکاری دانشگاهی در آمریکا، الگوریتم هوش مصنوعی "سینا" را توسعه دادهاند که با دقت بالا، بافت های سرطانی پستان را در مراحل اولیه شناسایی میکند.
کد خبر: ۲۱۴۷۶۱۳
۱۴۰۳/۰۷/۱۶
فراخوان یازدهمین کنگره زخم و ترمیم بافت سازمان جهاددانشگاهی علوم پزشکی تهران تا ۲۰ مهر تمدید شد.
کد خبر: ۲۱۴۲۰۰۲
۱۴۰۳/۰۷/۰۲
دانشمندان POSTECH با بازسازی ساختار چینوچروکها در بافت های انسانی، نقش کلیدی کمآبی و نیروهای فشاری را در تشکیل آنها شناسایی کردند.
کد خبر: ۲۱۴۱۳۲۱
۱۴۰۳/۰۷/۰۲
یک راس بز که به گله عشایر بالادست اسکر پناه آورده بود به رئیس اداره محیط زیست شهرستان بافت تحویل داده شد.
کد خبر: ۲۱۳۴۷۳۱
۱۴۰۳/۰۶/۱۳
نتایج یک پژوهش روشی ساده برای تولید آزمایشگاهی ارگانوئید کلیوی ارائه کرد که میتواند به عنوان مدلی برای بررسی تکوین کلیه، غربالگری داروها، آزمایش روشهای درمانی و سایر روشهای آزمایشگاهی مورد استفاده قرار گیرد.
کد خبر: ۲۱۱۹۶۸۶
۱۴۰۳/۰۵/۰۲
سازمان جهاددانشگاهی علومپزشکی تهران، یازدهمین کنگره بینالمللی زخم و ترمیم بافت را برگزار میکند.
کد خبر: ۲۱۱۴۵۱۹
۱۴۰۳/۰۴/۱۸
پژوهشگران یک شرکت دانشبنیان ایرانی فعال در حوزه تجهیزات پزشکی موفق شدند با تولید پانسمان ماتریکس کلاژن که شباهت ساختاری زیادی به بافت پوست دارد، ترمیم زخمهای بیماران را سرعت ببخشند.
کد خبر: ۲۰۶۷۳۱۸
۱۴۰۲/۱۲/۱۵
چین ساخت بستری (پلتفرم) نوآورانه برای تصویربرداری مولکولی و تشخیصدرمانی اختصاصی را در شهرک علمی خُواَیرو در شمال شرقی پکن آغاز کرده است.
کد خبر: ۲۰۶۲۵۷۳
۱۴۰۲/۱۲/۰۴
«تهیه داربست چندسازهای بر پایه کتیرا برای مهندسی بافت غضروف - استخوان» عنوان طرحی است که مریم دهقان نیری در قالب رساله دکتری با راهنمایی ابراهیم واشقانی فراهانی با حمایت بنیاد ملی علم ایران به انجام رسیده است.
کد خبر: ۱۵۱۶۷۲۳
۱۴۰۲/۰۶/۰۶
بنیاد ملی علم ایران با هدف جهتدهی علمی و حمایت ویژه از اندیشمندان و محققان برجسته کشور برای ورود و یا عمقبخشی به تحقیقات در عرصه کاربرد چاپگر زیستی در مهندسی بافت بنا دارد تا سقف سه برابر شرایط عادی طرحها این اولویت پژوهشی و تحقیقاتی را در قالب فراخوان عمومی مورد حمایت قرار دهد.
کد خبر: ۱۵۱۵۴۴۴
۱۴۰۲/۰۶/۰۳
پژوهشگران ایرانی موفق به تولید پتری دیش و فلاسک ویژه کشت سلول شدند.
کد خبر: ۱۵۱۰۴۲۳
۱۴۰۲/۰۵/۲۲
مدیرکل راه و شهرسازی فارس گفت: بازآفرینی شهری نظیر شیراز، نیاز به عزمی همه جانبه، مشابه تلاش و حرکتی شکل گرفته در قالب نهضت ملی مسکن دارد.
کد خبر: ۱۵۰۸۱۶۴
۱۴۰۲/۰۵/۱۶
مدیرعامل شرکت بازآفرینی شهری گفت: نوسازی و ساخت ۶۰۰ هزار واحد مسکونی در بافت فرسوده طی بازه زمانی چهار ساله در قالب طرح نهضت ملی برنامه ریزی شده که بازسازی و تحویل داده خواهد شد.
کد خبر: ۱۵۰۶۲۶۸
۱۴۰۲/۰۵/۱۱